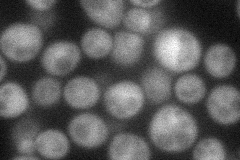
YLR151C
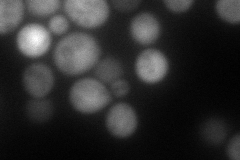
YLR151C
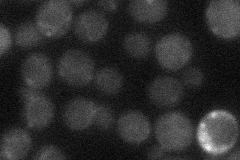
YLR151C
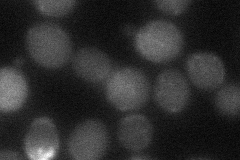
YLR151C
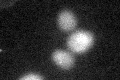
YLR151C
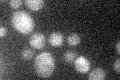
YLR151C

View description
Peroxisomal nudix pyrophosphatase with specificity for coenzyme A and CoA derivatives, may function to remove potentially toxic oxidized CoA disulfide from peroxisomes to maintain the capacity for beta-oxidation of fatty acids
Localization:
Intensity:
Fold change:
Significance:
-
C’ GFP library in SD

below threshold15.76 -
N' NOP1pr-GFP in SD
cytosol51.0572 -
N' TEF2pr-mCherry in SD
cytosol119.345 -
N' NATIVEpr-GFP in SD
below threshold21.4608 -
N' TEF2pr-VC and Cyto-VN in SD
cytosol30.8809 -
C’ GFP library in SD+DTT
cytosol16.971.07No -
C’ GFP library in SD+H2O2

cytosol18.921.19No -
C’ GFP library in Starvation Media
cytosol19.231.21No -
C’ GFP library on the background of Pup2-DaMP

N/A -
C’ GFP library on the background of CCT mutant

N/A0N/AYes
